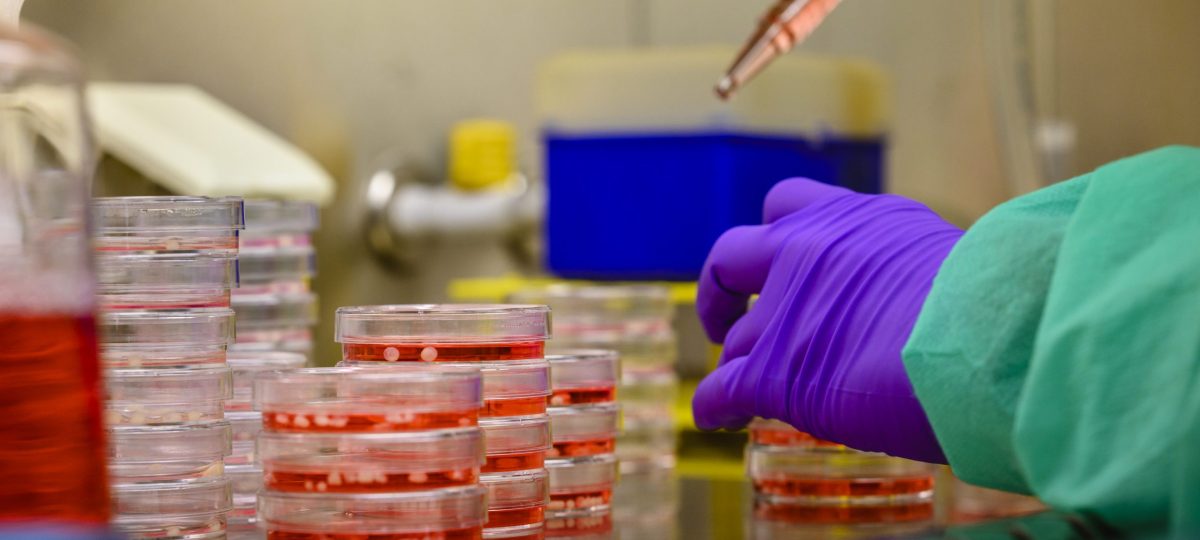

Een team onder leiding van prof. dr. Elly Hol van UMC Utrecht gaat onderzoeken hoe een ontstekingsreactie van hersencellen ontstaat. Deze reactie heet gliose. Wanneer gliose in de hersenen optreedt, verliezen cellen hun ondersteunende functie. Dat kan leiden tot verschillende hersenaandoeningen, zoals dementie, epilepsie en multiple sclerose (MS). Het samenwerkingsverband BRAINS** heeft €939.000 bijgedragen aan het onderzoek.
Aandoeningen beter begrijpen
In dit onderzoek wordt er samengewerkt tussen onderzoeksinstelling Utrecht UMC en het bedrijf Gliapharm. Er zullen met menselijke cellen goede kweekmodellen ontwikkeld voor hersenonderzoek. Hiermee begrijpen we beter hoe dementie en ook andere hersenaandoeningen ontstaan, zoals epilepsie en MS. Met nieuwe technieken bestuderen de onderzoekers patiënt-specifieke veranderingen. Zo wil deze onderzoeksgroep gerichtere medicijnen ontwikkelen om gliose tegen te gaan.
Wat is gliose?
Gliose ontstaat bij veel hersenziekten. Als cellen in de hersenen overprikkeld zijn, beschadigd raken of dood gaan, volgt er een ontstekingsreactie in de hersencellen die glia wordt genoemd. In gezonde hersenen zorgt glia ervoor dat neuronen optimaal kunnen functioneren. Als er gliose optreedt, verliezen de gliacellen hun ondersteunende taken. Dit verslechtert de communicatie tussen neuronen en zo ontstaat dementie, epilepsie of MS. Daarnaast komt gliose ook bij veel andere hersenaandoeningen voor.
Waarom steunt BRAINS dit onderzoek?
Wanneer er meer kennis is over de oorzaak van hersenaandoeningen, krijgen patiënten eerder hun diagnose en behandeling. Het aandoeningoverstijgend onderzoek in BRAINS verbetert op die manier de kwaliteit van leven voor mensen met een hersenaandoening. Door de krachten te bundelen in deze samenwerking met vijf gezondheidsfondsen behalen we dit doel sneller.
Meer over het onderzoek

Gliose is veel bestudeerd in de hersenen van overleden patiënten. Maar om te onderzoeken wat de gevolgen zijn van gliose en hoe we gliose kunnen tegengaan, zijn levende cellen nodig. In dit onderzoek gebruiken wetenschappers een techniek die geïnduceerde pluripotente stamceltechnologie (iPSC-technologie) heet. Met deze techniek kunnen ze gewone lichaamscellen omzetten in stamcellen en daaruit vervolgens hersencellen maken. Zo kunnen de onderzoekers hersencellen van patiënten bestuderen. Dit is een zeer belangrijke stap vooruit, omdat ze nu patiënt-specifieke veranderingen per cel kunnen bestuderen. Daarmee kunnen ze nieuwe patiëntgerichte medicatie ontwikkelen om gliose tegen te gaan.
Hoe pakken ze dit aan?

De onderzoekers ontwikkelen stamcelmodellen en tools (technische hulpmiddelen) om het functioneren van hersencellen te bestuderen. Op verschillende niveaus beoordelen zij de ontstekingsreacties in hersencellen. Daar horen ook de veranderingen in onderling celcontact bij. Door de stoffen waar het om gaat duidelijk zichtbaar te maken, is het eenvoudiger om te bepalen wat er gebeurt in de cellen.
Welke resultaten verwachten de onderzoekers?
Momenteel bestaat er geen genezing voor dementie, terwijl die ziekte wereldwijd steeds meer voorkomt. Zeker nu mensen steeds ouder worden, heeft dementie meer impact op de samenleving. Met de resultaten van dit onderzoek wordt het mogelijk om beter te bepalen welke medicijnen de ziekte kunnen stoppen of omkeren. Daarnaast zorgt meer kennis over gliose ook voor nieuwe behandelmogelijkheden voor andere hersenaandoeningen.
“Voorheen richtte het meeste hersenonderzoek zich op zenuwcellen bij hersenaandoeningen. Gelukkig komt er nu steeds meer aandacht voor andere hersencellen en gliose, wat nieuwe kansen biedt voor de ontwikkeling van medicijnen. In ons lab werkt een team aan innovatieve technieken om gliose beter te kunnen bestuderen. Samen met GliaPharm onderzoeken we nieuwe medicijnen die specifiek gericht zijn op gliose, met als doel mensen met hersenaandoeningen in de toekomst beter te kunnen behandelen. We zijn erg blij met de financiering van BRAINS, die deze samenwerking mogelijk maakt.” aldus prof. dr. Elly Hol, hoogleraar gliabiologie van hersenziekten UMC Utrecht.
Hoe ver is het onderzoek?
Het onderzoek is gestart in 2024 en duurt vier jaar. Als er in de tussentijd resultaten zijn, dan wordt deze pagina aangevuld.
Wat is de volgende stap?
Als de onderzoekers begrijpen hoe ontstekingsreacties in de hersenen werken, is de basis gelegd voor nieuwe behandelingen. Het ontwikkelen van nieuwe medicijnen kan pas als duidelijk is wat er gebeurt als ze bij ontstoken hersencellen aankomen. Een volgende stap na dit onderzoek zou daarom het ontwikkelen en testen van nieuwe medicijnen kunnen zijn.
**Binnen het samenwerkingsverband BRAINS bundelen Alzheimer Nederland, EpilepsieNL, Hersenstichting, ParkinsonNL en Stichting MS Research de krachten. Dit onderzoek is medegefinancierd met PPS-financiering door Health~Holland, Topsector Life Sciences & Health, dat beschikbaar is gesteld aan BRAINS ter stimulering van publiek-private samenwerkingen.